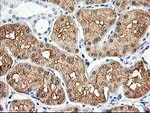
ALDOB Antibody in Immunohistochemistry (Paraffin) (IHC (P))

Search
OriGene
ALDOB Monoclonal Antibody (OTI3E10), TrueMAB™
{{$productOrderCtrl.translations['antibody.pdp.commerceCard.promotion.promotions']}}
{{$productOrderCtrl.translations['antibody.pdp.commerceCard.promotion.viewpromo']}}
{{$productOrderCtrl.translations['antibody.pdp.commerceCard.promotion.promocode']}}: {{promo.promoCode}} {{promo.promoTitle}} {{promo.promoDescription}}. {{$productOrderCtrl.translations['antibody.pdp.commerceCard.promotion.learnmore']}}
产品信息
TA502909
种属反应
宿主/亚型
分类
类型
克隆号
抗原
偶联物
形式
浓度
规格
纯化类型
保存液
内含物
保存条件
运输条件
靶标信息
Fructose-1,6-bisphosphate aldolase is a tetrameric glycolytic enzyme that catalyzes the reversible conversion of fructose-1,6-bisphosphate to glyceraldehyde 3-phosphate and dihydroxyacetone phosphate. Vertebrates have 3 aldolase isozymes which are distinguished by their electrophoretic and catalytic properties. Differences indicate that aldolases A, B, and C are distinct proteins, the products of a family of related 'housekeeping' genes exhibiting developmentally regulated expression of the different isozymes. The developing embryo produces aldolase A, which is produced in even greater amounts in adult muscle where it can be as much as 5% of total cellular protein. In adult liver, kidney and intestine, aldolase A expression is repressed and aldolase B is produced. In brain and other nervous tissue, aldolase A and C are expressed about equally. There is a high degree of homology between aldolase A and C. Defects in ALDOB cause hereditary fructose intolerance.
仅用于科研。不用于诊断过程。未经明确授权不得转售。
篇参考文献 (0)
生物信息学
蛋白别名: aldolase 2; aldolase B, fructose-bisphosphatase; aldolase B, fructose-bisphosphate; Fructose-bisphosphate aldolase B; Liver-type aldolase; unnamed protein product
基因别名: ALDB; ALDO2; ALDOB
UniProt ID: (Human) P05062
Entrez Gene ID: (Human) 229